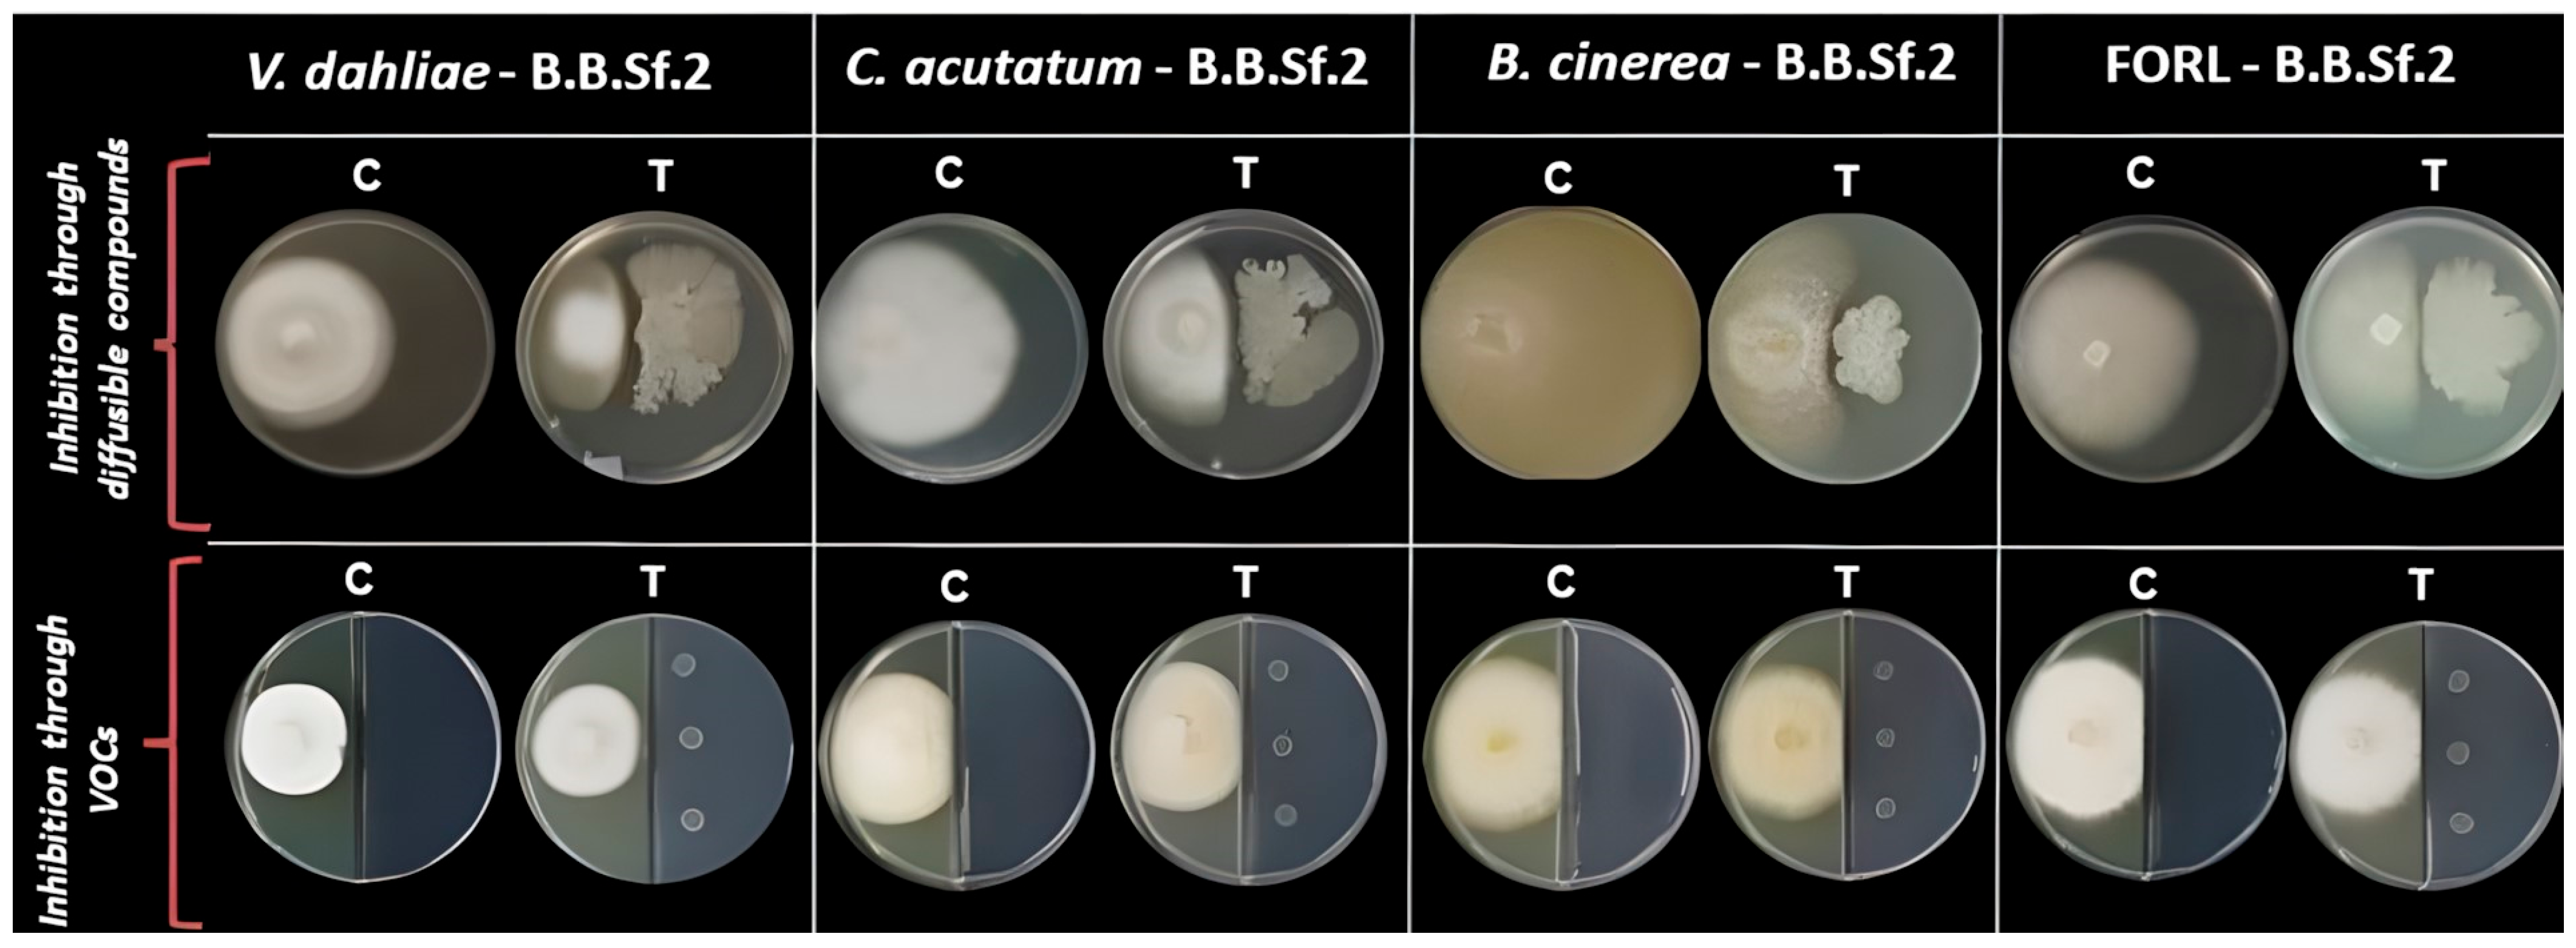

Unveiling the Genomic Basis of Antagonism and Plant Growth Promotion in the Novel Endophyte Bacillus velezensis Strain B.B.Sf.2
Abstract
1. Introduction
2. Materials and Methods
2.1. Plant Material and Isolation of Endophytic Bacterial Strains
2.2. Examination of Plant-Growth-Promoting and Colonization-Related Traits
2.2.1. Siderophore Production Assay
2.2.2. Phosphate Solubilization Assay
2.2.3. Acetoin Production Assay
2.2.4. Cellulase Production Assay
2.2.5. Urease Production Assay
2.2.6. Protease Production Assay
2.2.7. Motility Assays (Swarming and Swimming)
2.2.8. Biofilm Formation Assay
2.2.9. Indole-Related Compounds Production Assay and Quantitative Analysis of IAA Production
2.3. Evaluation of Antagonistic Activity
2.4. In Vitro Plant Growth Effect on A. thaliana Col-0 Seedlings
2.5. In Vivo Biological Control Against Colletotrichum acutatum and Botrytis cinerea on Detached Fruits
2.6. Extraction of Agar-Diffusible Compounds and Bioactivity Through TLC-Bioautography Testing
2.7. Phylogenetic Taxonomy on 16S rRNA Sequence
2.8. Whole-Genome Sequencing (WGS)
2.9. In Silico Genomic Analysis
2.10. Statistical Analysis
3. Results
3.1. Isolation of Endophytic Bacteria from Salvia fruticosa
3.2. In Vitro Traits Associated with B.B.Sf.2 Plant Growth Promotion and Biocontrol Potential
3.3. Phylogenomic Taxonomy of the Bacterial Endophytic Strain B.B.Sf.2
3.4. Genetic Basis of Plant Growth, Colonization, and Biological Control Activity of the B.B.Sf.2 Strain
3.5. Detection of Secondary Metabolites Gene Clusters
3.6. TLC-Bioautography Assay
3.7. Biological Control Activity of the B.B.Sf.2 Strain on Detached Fruits
3.8. B.B.Sf.2 Possesses Plant-Growth-Promoting Potential on the Model Plant A. thaliana In Vitro
4. Discussion
4.1. Genome Mining and Functional Insights
4.2. Biosynthetic Gene Clusters and Secondary Metabolite Potential
4.3. Secondary Metabolite and Antimicrobial Potential of B.B.Sf.2
5. Conclusions
Supplementary Materials
Author Contributions
Funding
Institutional Review Board Statement
Informed Consent Statement
Data Availability Statement
Conflicts of Interest
References
- Battisi, D.S.; Naylor, R.L. Historical Warnings of Future Food Insecurity with Unprecented Seasonal Heat, Science. Sci. J. Sci. 2009, 323, 240–244. [Google Scholar]
- Berg, G. Plant–microbe interactions promoting plant growth and health: Perspectives for controlled use of microorganisms in agriculture. Appl. Microbiol. Biotechnol. 2009, 84, 11–18. [Google Scholar] [CrossRef] [PubMed]
- Kumar, A.; Verma, J.P. Does plant-Microbe interaction confer stress tolerance in plants: A review? Microbiol. Res. 2018, 207, 41–52. [Google Scholar] [CrossRef] [PubMed]
- Leach, A.W.; Mumford, J.D. Pesticide Environmental Accounting: A method for assessing the external costs of individual pesticide applications. Environ. Pollut. 2008, 151, 139–147. [Google Scholar] [CrossRef] [PubMed]
- Meena, R.S.; Kumar, S.; Datta, R.; Lal, R.; Vijayakumar, V.; Brtnicky, M.; Sharma, M.P.; Yadav, G.S.; Jhariya, M.K.; Jangir, C.K. Impact of agrochemicals on soil microbiota and management: A review. Land 2020, 9, 34. [Google Scholar] [CrossRef]
- Mishra, J.; Singh, R.; Arora, N.K. Plant Growth-Promoting Microbes: Diverse Roles in Agriculture and Environmental Sustainability. In Probiotics and Plant Health; Kumar, V., Kumar, M., Sharma, S., Prasad, R., Eds.; Springer: Singapore, 2017; pp. 71–111. [Google Scholar]
- Abhilash, P.C.; Dubey, R.K.; Tripathi, V.; Gupta, V.K.; Singh, H.B. Plant growth-promoting microorganisms for environmental sustainability. Trends Biotechnol. 2016, 34, 847–850. [Google Scholar] [CrossRef]
- Yadav, A.N.; Kumar, R.; Kumar, S.; Kumar, V.; Sugitha, T.; Singh, B.; Chauahan, V.S.; Dhaliwal, H.S.; Saxena, A.K. Beneficial microbiomes: Biodiversity and potential biotechnological applications for sustainable agriculture and human health. J. Appl. Biol. Biotechnol. 2017, 5, 45–57. [Google Scholar]
- Lugtenberg, B.J.; Chin-A-Woeng, T.F.; Bloemberg, G.V. Microbe-plant interactions: Principles and mechanisms. Antonie Van Leeuwenhoek 2002, 81, 373–383. [Google Scholar] [CrossRef]
- El-Saadony, M.T.; Saad, A.M.; Soliman, S.M.; Salem, H.M.; Ahmed, A.I.; Mahmood, M.; El-Tahan, A.M.; Ebrahim, A.A.M.; El-Mageed, T.A.A.; Negm, S.H.; et al. Plant growth-promoting microorganisms as biocontrol agents of plant diseases: Mechanisms, challenges and future perspectives. Front. Plant Sci. 2022, 13, 923880. [Google Scholar] [CrossRef]
- Santoyo, G.; Moreno-Hagelsieb, G.; del Carmen Orozco-Mosqueda, M.; Glick, B.R. Plant growth-promoting bacterial endophytes. Microbiol. Res. 2016, 183, 92–99. [Google Scholar] [CrossRef]
- Liu, X.; Dou, G.; Ma, Y. Potential of endophytes from medicinal plants for biocontrol and plant growth promotion. J. Gen. Plant Pathol. 2016, 82, 165–173. [Google Scholar] [CrossRef]
- Wu, W.; Chen, W.; Liu, S.; Wu, J.; Zhu, Y.; Qin, L.; Zhu, B. Beneficial relationships between endophytic bacteria and medicinal plants. Front. Plant Sci. 2021, 12, 646146. [Google Scholar] [CrossRef] [PubMed]
- Adeleke, B.S.; Babalola, O.O.; Glick, B.R. Plant growth-promoting root-colonizing bacterial endophytes. Rhizosphere 2021, 20, 100433. [Google Scholar] [CrossRef]
- Kumari, M.; Qureshi, K.A.; Jaremko, M.; White, J.F.; Singh, S.K.; Sharma, V.K.; Singh, K.K.; Santoyo, G.; Puopolo, G.; Kumar, A. Deciphering the role of endophytic microbiome in postharvest diseases management of fruits: Opportunity areas in commercial up-scale production. Front. Plant Sci. 2022, 13, 1026575. [Google Scholar] [CrossRef] [PubMed]
- Márquez, R.; Blanco, E.L.; Aranguren, Y. Bacillus strain selection with plant growth-promoting mechanisms as potential elicitors of systemic resistance to gray mold in pepper plants. Saudi J. Biol. Sci. 2020, 27, 1913–1922. [Google Scholar] [CrossRef] [PubMed]
- Fira, D.; Dimkić, I.; Berić, T.; Lozo, J.; Stanković, S. Biological control of plant pathogens by Bacillus species. J. Biotechnol. 2018, 285, 44–55. [Google Scholar] [CrossRef]
- Lopes, R.; Tsui, S.; Gonçalves, P.J.; de Queiroz, M.V. A look into a multifunctional toolbox: Endophytic Bacillus species provide broad and underexploited benefits for plants. World J. Microbiol. Biotechnol. 2018, 34, 1–10. [Google Scholar] [CrossRef]
- Miljaković, D.; Marinković, J.; Balešević-Tubić, S. The significance of Bacillus spp. in disease suppression and growth promotion of field and vegetable crops. Microorganisms 2020, 8, 1037. [Google Scholar] [CrossRef]
- Iqbal, S.; Begum, F.; Rabaan, A.A.; Aljeldah, M.; Al Shammari, B.R.; Alawfi, A.; Alshengeti, A.; Sulaiman, T.; Khan, A. Classification and Multifaceted Potential of Secondary Metabolites Produced by Bacillus subtilis Group: A Comprehensive Review. Molecules 2023, 28, 927. [Google Scholar] [CrossRef]
- Kusari, P.; Kusari, S.; Spiteller, M.; Kayser, O. Endophytic fungi harbored in Cannabis sativa L.: Diversity and potential as biocontrol agents against host plant-specific phytopathogens. Fungal Divers. 2013, 60, 137–151. [Google Scholar] [CrossRef]
- Schwyn, B.; Neilands, J.B. Universal chemical assay for the detection and determination of siderophores. Anal. Biochem. 1987, 160, 47–56. [Google Scholar] [CrossRef] [PubMed]
- Pikovskaya, R.I. Mobilization of Phosphorus in Soil Connection with the Vital Activity of Some Microbial Species. Microbiology 1948, 17, 362–370. [Google Scholar]
- Baysal, Ö.; Lai, D.; Xu, H.H.; Siragusa, M.; Çalışkan, M.; Carimi, F.; Tör, M. A proteomic approach provides new insights into the control of soil-borne plant pathogens by Bacillus species. PLoS ONE 2013, 8, e53182. [Google Scholar] [CrossRef]
- Xu, S.J.; Kim, B.S. Biocontrol of Fusarium crown and root rot and promotion of growth of tomato by Paenibacillus strains isolated from soil. Mycobiology 2014, 42, 158–166. [Google Scholar] [CrossRef] [PubMed]
- ISO 6579:2017; Microbiology of the Food Chain—Horizontal Method for the Detection, Enumeration and Serotyping of Salmonella. International Organization for Standardization (ISO): Geneva, Switzerland, 2017.
- ISO 19250:2010; Water Quality—Detection of Salmonella. International Organization for Standardization (ISO): Geneva, Switzerland, 2010.
- Mobley, H.L.; Hausinger, R.P. Microbial ureases: Significance, regulation, and molecular characterization. Microbiol. Rev. 1989, 53, 85–108. [Google Scholar] [CrossRef]
- Kumar, R.S.; Ayyadurai, N.; Pandiaraja, P.; Reddy, A.; Venkateswarlu, Y.; Prakash, O.; Sakthivel, N. Characterization of antifungal metabolite produced by a new strain Pseudomonas aeruginosa PUPa3 that exhibits broad-spectrum antifungal activity and biofertilizing traits. J. Appl. Microbiol. 2005, 98, 145–154. [Google Scholar] [CrossRef] [PubMed]
- O’Toole, G.A.; Kolter, R. Initiation of biofilm formation in Pseudomonas fluorescens WCS365 proceeds via multiple, convergent signalling pathways: A genetic analysis. Mol. Microbiol. 1998, 28, 449–461. [Google Scholar] [CrossRef]
- Baldan, E.; Nigris, S.; Romualdi, C.; D’Alessandro, S.; Clocchiatti, A.; Zottini, M.; Stevanato, P.; Squartini, A.; Baldan, B. Beneficial bacteria isolated from grapevine inner tissues shape Arabidopsis thaliana roots. PLoS ONE 2015, 10, e0140252. [Google Scholar] [CrossRef]
- Ehmann, A. The Van Urk-Salkowski reagent—A sensitive and specific chromogenic reagent for silica gel thin-layer chromatographic detection and identification of indole derivatives. J. Chromatogr. 1977, 132, 267–276. [Google Scholar] [CrossRef]
- Li, W.; Sun, L.; Wu, H.; Gu, W.; Lu, Y.; Liu, C.; Zhang, J.; Li, W.; Zhou, C.; Geng, H.; et al. Bacillus velezensis YXDHD1-7 Prevents Early Blight Disease by Promoting Growth and Enhancing Defense Enzyme Activities in Tomato Plants. Microorganisms 2024, 12, 921. [Google Scholar] [CrossRef]
- Lamsal, K.; Kim, S.W.; Kim, Y.S.; Lee, Y.S. Application of rhizobacteria for plant growth promotion effect and biocontrol of anthracnose caused by Colletotrichum acutatum on pepper. Mycobiology 2012, 40, 244–251. [Google Scholar] [CrossRef] [PubMed]
- Hunziker, L.; Bönisch, D.; Groenhagen, U.; Bailly, A.; Schulz, S.; Weisskopf, L. Pseudomonas strains naturally associated with potato plants produce volatiles with high potential for inhibition of Phytophthora infestans. Appl. Environ. Microbiol. 2015, 81, 821–830. [Google Scholar] [CrossRef]
- Yuan, J.; Raza, W.; Shen, Q.; Huang, Q. Antifungal activity of Bacillus amyloliquefaciens NJN-6 volatile compounds against Fusarium oxysporum f. sp. cubense. Appl. Environ. Microbiol. 2012, 78, 5942–5944. [Google Scholar] [CrossRef] [PubMed]
- Palacio-Rodríguez, R.; Coria-Arellano, J.L.; López-Bucio, J.; Sánchez-Salas, J.; Muro-Pérez, G.; Castañeda-Gaytán, G.; Sáenz-Mata, J. Halophilic rhizobacteria from Distichlis spicata promote growth and improve salt tolerance in heterologous plant hosts. Symbiosis 2017, 73, 179–189. [Google Scholar] [CrossRef]
- Asari, S.; Matzén, S.; Petersen, M.A.; Bejai, S.; Meijer, J. Multiple effects of Bacillus amyloliquefaciens volatile compounds: Plant growth promotion and growth inhibition of phytopathogens. FEMS Microbiol. Ecol. 2016, 92, fiw070. [Google Scholar] [CrossRef] [PubMed]
- Lian, Q.; Zhang, J.; Gan, L.; Ma, Q.; Zong, Z.; Wang, Y. The Biocontrol Efficacy of Streptomyces pratensis LMM15 on Botrytis cinerea in Tomato. Biomed. Res. Int. 2017, 2017, 9486794. [Google Scholar] [CrossRef]
- Essghaier, B.; Fardeau, M.L.; Cayol, J.L.; Hajlaoui, M.R.; Boudabous, A.; Jijakli, H.; Sadfi-Zouaoui, N. Biological control of grey mould in strawberry fruits by halophilic bacteria. J. Appl. Microbiol. 2009, 106, 833–846. [Google Scholar] [CrossRef]
- Bertrand, S.; Schumpp, O.; Bohni, N.; Bujard, A.; Azzollini, A.; Monod, M.; Gindro, K.; Wolfender, J.L. Detection of metabolite induction in fungal co-cultures on solid media by high-throughput differential ultra-high pressure liquid chromatography–time-of-flight mass spectrometry fingerprinting. J. Chromatogr. A 2013, 1292, 219–228. [Google Scholar] [CrossRef]
- Costa, J.H.; Wassano, C.I.; Angolini, C.F.F.; Scherlach, K.; Hertweck, C.; Pacheco Fill, T. Antifungal potential of secondary metabolites involved in the interaction between citrus pathogens. Sci. Rep. 2019, 9, 18647. [Google Scholar] [CrossRef]
- Calvo, H.; Mendiara, I.; Arias, E.; Blanco, D.; Venturini, M. The role of iturin A from B. amyloliquefaciens BUZ-14 in the inhibition of the most common postharvest fruit rots. Food. Microbiol. 2019, 82, 62–69. [Google Scholar] [CrossRef]
- Weisburg, W.G.; Barns, S.M.; Pelletier, D.A.; Lane, D.J. 16S ribosomal DNA amplification for phylogenetic study. J. Bacteriol. 1991, 173, 697–703. [Google Scholar] [CrossRef] [PubMed]
- Bankevich, A.; Nurk, S.; Antipov, D.; Gurevich, A.A.; Dvorkin, M.; Kulikov, A.S.; Lesin, V.M.; Nikolenko, S.I.; Pham, S.; Prjibelski, A.D.; et al. SPAdes: A new genome assembly algorithm and its applications to single-cell sequencing. J. Comput. Bio. 2012, 19, 455–477. [Google Scholar] [CrossRef] [PubMed]
- Yoon, S.H.; Ha, S.M.; Kwon, S.; Lim, J.; Kim, Y.; Seo, H.; Chun, J. Introducing EzBioCloud: A taxonomically united database of 16S rRNA gene sequences and whole-genome assemblies. Int. J. Syst. Evol. Microbiol. 2017, 67, 1613. [Google Scholar] [CrossRef]
- Meier-Kolthoff, J.P.; Auch, A.F.; Klenk, H.P.; Göker, M. Genome sequence-based species delimitation with confidence intervals and improved distance functions. BMC Bioinform. 2013, 14, 60. [Google Scholar] [CrossRef]
- Lefort, V.; Desper, R.; Gascuel, O. FastME 2.0: A comprehensive, accurate, and fast distance-based phylogeny inference program. Mol. Biol. Evol. 2015, 32, 2798–2800. [Google Scholar] [CrossRef] [PubMed]
- Zhang, H.; Yohe, T.; Huang, L.; Entwistle, S.; Wu, P.; Yang, Z.; Busk, P.K.; Xu, Y.; Yin, Y. dbCAN2: A meta server for automated carbohydrate-active enzyme annotation. Nucleic Acids Res. 2018, 46, W95–W101. [Google Scholar] [CrossRef]
- Blin, K.; Shaw, S.; Steinke, K.; Villebro, R.; Ziemert, N.; Lee, S.Y.; Medema, M.H.; Weber, T. antiSMASH 5.0: Updates to the secondary metabolite genome mining pipeline. Nucleic. Acids. Res. 2019, 47, W81–W87. [Google Scholar] [CrossRef]
- Medema, M.H.; Kottmann, R.; Yilmaz, P.; Cummings, M.; Biggins, J.B.; Blin, K.; De Bruijn, I.; Chooi, Y.H.; Claesen, J.; Coates, R.C.; et al. Minimum information about a biosynthetic gene cluster. Nat. Chem. Biol. 2015, 11, 625–631. [Google Scholar] [CrossRef]
- Castronovo, L.M.; Vassallo, A.; Mengoni, A.; Miceli, E.; Bogani, P.; Firenzuoli, F.; Fani, R.; Maggini, V. Medicinal plants and their bacterial microbiota: A review on antimicrobial compounds production for plant and human health. Pathogens 2021, 10, 106. [Google Scholar] [CrossRef]
- Aswani, R.; Jishma, P.; Radhakrishnan, E.K. Endophytic bacteria from the medicinal plants and their potential applications. In Microbial Endophytes: Prospects for Sustainable Agriculture; Kumar, A., Singh, V.K., Eds.; Woodhead Publishing: Sawston, Cambridge, UK, 2020; pp. 15–36. [Google Scholar]
- Etesami, H.; Jeong, B.R.; Glick, B.R. Potential use of Bacillus spp. as an effective biostimulant against abiotic stresses in crops—A review. Curr. Res. Biotechnol. 2023, 5, 100128. [Google Scholar] [CrossRef]
- Shafi, J.; Tian, H.; Ji, M. Bacillus species as versatile weapons for plant pathogens: A review. Biotechnol. Biotechnol. Equip. 2017, 31, 446–459. [Google Scholar] [CrossRef]
- Dunlap, C.A. Taxonomy of registered Bacillus spp. strains used as plant pathogen antagonists. Biol. Control 2019, 134, 82–86. [Google Scholar] [CrossRef]
- Papageorgiou, V.; Gardeli, C.; Mallouchos, A.; Papaioannou, M.; Komaitis, M. Variation of the chemical profile and antioxidant behavior of Rosmarinus officinalis L. and Salvia fruticosa Miller grown in Greece. J. Agric. Food Chem. 2008, 56, 7254–7264. [Google Scholar] [CrossRef] [PubMed]
- Duletić-Laušević, S.; Aradski, A.A.; Šavikin, K.; Knežević, A.; Milutinović, M.; Stević, T.; Vukojević, J.; Marković, S.; Marin, P.D. Composition and biological activities of Libyan Salvia fruticosa Mill. and S. lanigera Poir. extracts. S. Afr. J. Bot. 2018, 117, 101–109. [Google Scholar] [CrossRef]
- Zimowska, B.; Bielecka, M.; Abramczyk, B.; Nicoletti, R. Bioactive products from endophytic fungi of sages (Salvia spp). Agriculture 2020, 10, 543. [Google Scholar] [CrossRef]
- Egamberdieva, D.; Eshboev, F.; Shukurov, O.; Alaylar, B.; Arora, N.K. Bacterial bioprotectants: Biocontrol traits and induced resistance to phytopathogens. Microbiol. Res. 2023, 14, 689–703. [Google Scholar] [CrossRef]
- Fadiji, A.E.; Babalola, O.O. Elucidating mechanisms of endophytes used in plant protection and other bioactivities with multifunctional prospects. Front. Bioeng. Biotechnol. 2020, 8, 467. [Google Scholar] [CrossRef]
- Danhorn, T.; Fuqua, C. Biofilm formation by plant-associated bacteria. Annu. Rev. Microbiol. 2007, 61, 401–422. [Google Scholar] [CrossRef]
- Venieraki, A.; Tsalgatidou, P.C.; Georgakopoulos, D.; Dimou, M.; Katinakis, P. Swarming motility in plant-associated bacteria. Hell. Plant Prot. J. 2016, 9, 16–27. [Google Scholar] [CrossRef]
- Rooney, A.P.; Price, N.P.; Ehrhardt, C.; Swezey, J.L.; Bannan, J.D. Phylogeny and molecular taxonomy of the Bacillus subtilis species complex and description of Bacillus subtilis subsp. inaquosorum subsp. nov. Int. J. SystEvolMicrobiol. 2009, 59, 2429–2436. [Google Scholar]
- Gilchrist, C.A.; Turner, S.D.; Riley, M.F.; Petri, W.A., Jr.; Hewlett, E.L. Whole-genome sequencing in outbreak analysis. Clin Microbiol Rev. 2015, 28, 541–563. [Google Scholar] [CrossRef] [PubMed]
- Zaid, D.S.; Cai, S.; Hu, C.; Li, Z.; Li, Y. Comparative genome analysis reveals phylogenetic identity of Bacillus velezensis HNA3 and genomic insights into its plant growth promotion and biocontrol effects. Microbiol. Spectr. 2022, 10, e02169-21. [Google Scholar] [CrossRef] [PubMed]
- Tang, J.; Li, Y.; Zhang, L.; Mu, J.; Jiang, Y.; Fu, H.; Zhang, Y.; Cui, H.; Yu, X.; Ye, Z. Biosynthetic Pathways and Functions of Indole-3-Acetic Acid in Microorganisms. Microorganisms 2023, 11, 2077. [Google Scholar] [CrossRef] [PubMed]
- Hibbing, M.E.; Fuqua, C.; Parsek, M.R.; Peterson, S.B. Bacterial competition: Surviving and thriving in the microbial jungle. Nat. Rev. Microbiol. 2010, 8, 15–25. [Google Scholar] [CrossRef]
- Mishra, A.K.; Sharma, K.; Misra, R.S. Elicitor recognition, signal transduction and induced resistance in plants. J. Plant Interact. 2012, 7, 95–120. [Google Scholar] [CrossRef]
- Mikitova, V.; Jopcik, M.; Rajninec, M.; Libantova, J. Complex transcription regulation of acidic chitinase suggests fine-tuning of digestive processes in Droserabinata. Planta 2025, 261, 2. [Google Scholar] [CrossRef]
- Fukamizo, T.; Shinya, S. Chitin/Chitosan-Active Enzymes Involved in Plant-Microbe Interactions. Adv. Exp. Med. Biol. 2019, 1142, 253–272. [Google Scholar]
- Carro, L.; Menéndez, E. Knock, knock-let the bacteria in: Enzymatic potential of plant associated bacteria. In Molecular Aspects of Plant Beneficial Microbes in Agriculture; Academic Press: Cambridge, MA, USA, 2020; pp. 169–178. [Google Scholar]
- Phillips, A.M.; Sanchez, S.; Sysoeva, T.A.; Burton, B.M.; Kearns, D.B. Molecular and Cell Biological Analysis of SwrB in Bacillus subtilis. J. Bacteriol. 2021, 203, e0022721. [Google Scholar] [CrossRef]
- Kearns, D.B.; Chu, F.; Rudner, R.; Losick, R. Genes governing swarming in Bacillus subtilis and evidence for a phase variation mechanism controlling surface motility. Mol. Microbiol. 2004, 52, 357–369. [Google Scholar] [CrossRef]
- Ghelardi, E.; Salvetti, S.; Ceragioli, M.; Gueye, S.A.; Celandroni, F.; Senesi, S. Contribution of surfactin and SwrA to flagellin expression, swimming, and surface motility in Bacillus subtilis. Appl. Environ. Microbiol. 2012, 78, 6540–6544. [Google Scholar] [CrossRef]
- Dąbrowska, G.B.; Tylman-Mojżeszek, W.; Mierek-Adamska, A.; Richert, A.; Hrynkiewicz, K. Potential of Serratia plymuthica IV-11-34 strain for biodegradation of polylactide and poly (ethylene terephthalate). Int. J. Biol. Macromol. 2021, 193, 145–153. [Google Scholar] [CrossRef] [PubMed]
- Winkelman, J.T.; Bree, A.C.; Bate, A.R.; Eichenberger, P.; Gourse, R.L.; Kearns, D.B. RemA is a DNA-binding protein that activates biofilm matrix gene expression in Bacillus subtilis. Mol. Microbiol. 2013, 88, 984–997. [Google Scholar] [CrossRef] [PubMed]
- Carabetta, V.J.; Tanner, A.W.; Greco, T.M.; Defrancesco, M.; Cristea, I.M.; Dubnau, D. A complex of YlbF, YmcA and YaaT regulates sporulation, competence and biofilm formation by accelerating the phosphorylation of Spo0A. Mol. Microbiol. 2013, 88, 283–300. [Google Scholar] [CrossRef]
- Guttenplan, S.B.; Kearns, D.B. Regulation of flagellar motility during biofilm formation. FEMS Microbiol. Rev. 2013, 37, 849–871. [Google Scholar] [CrossRef] [PubMed]
- Ochman, H.; Lawrence, J.G.; Groisman, E.A. Lateral gene transfer and the nature of bacterial innovation. Nature 2000, 405, 299–304. [Google Scholar] [CrossRef]
- Li, Z.; Song, C.; Yi, Y.; Kuipers, O.P. Characterization of plant growth-promoting rhizobacteria from perennial ryegrass and genome mining of novel antimicrobial gene clusters. BMC Genom. 2020, 21, 157. [Google Scholar] [CrossRef]
- Wang, D.; Xu, Z.; Zhang, G.; Xia, L.; Dong, X.; Li, Q.; Liles, M.R.; Shao, J.; Shen, Q.; Zhang, R. A genomic island in a plant beneficial rhizobacterium encodes novel antimicrobial fatty acids and a self-protection shield to enhance its competition. Environ. Microbiol. 2019, 21, 3455–3471. [Google Scholar] [CrossRef]
- Su, Z.; Liu, G.; Liu, X.; Li, S.; Lu, X.; Wang, P.; Zhao, W.; Zhang, X.; Dong, L.; Qu, Y. Functional analyses of the Bacillus velezensis HMB26553 genome provide evidence that its genes are potentially related to the promotion of plant growth and prevention of cotton Rhizoctonia damping-off. Cells 2023, 12, 1301. [Google Scholar] [CrossRef]
- Llewellyn, N.M.; Li, Y.; Spencer, J.B. Biosynthesis of butirosin: Transfer and deprotection of the unique amino acid side chain. Chem. Biol. 2007, 14, 379–386. [Google Scholar] [CrossRef]
- Zhao, X.; Kuipers, O.P. Identification and classification of known and putative antimicrobial compounds produced by a wide variety of Bacillales species. BMC Genom. 2016, 17, 882. [Google Scholar] [CrossRef]
- Wu, L.; Wu, H.; Chen, L.; Yu, X.; Borriss, R.; Gao, X. Difficidin and bacilysin from Bacillus amyloliquefaciens FZB42 have antibacterial activity against Xanthomonas oryzae rice pathogens. Sci. Rep. 2015, 5, 12975. [Google Scholar] [CrossRef] [PubMed]
- Aleti, G.; Sessitsch, A.; Brader, G. Genome mining: Prediction of lipopeptides and polyketides from Bacillus and related Firmicutes. Comput. Struct. Biotechnol. J. 2015, 13, 192–203. [Google Scholar] [CrossRef] [PubMed]
- Schmitz, S.; Hoffmann, A.; Szekat, C.; Rudd, B.; Bierbaum, G. The lantibiotic mersacidin is an autoinducing peptide. Appl. Environ. Microbiol. 2006, 72, 7270–7277. [Google Scholar] [CrossRef] [PubMed]
- Caulier, S.; Nannan, C.; Gillis, A.; Licciardi, F.; Bragard, C.; Mahillon, J. Overview of the Antimicrobial Compounds Produced by Members of the Bacillus subtilis Group. Front Microbiol. 2019, 10, 302. [Google Scholar] [CrossRef]
- Schneider, K.; Chen, X.H.; Vater, J.; Franke, P.; Nicholson, G.; Borriss, R.; Süssmuth, R.D. Macrolactin is the polyketide biosynthesis product of the pks2 cluster of Bacillus amyloliquefaciens FZB42. J. Nat. Prod. 2007, 70, 1417–1423. [Google Scholar] [CrossRef]
- Chen, J.; Liu, T.; Wei, M.; Zhu, Z.; Liu, W.; Zhang, Z. Macrolactin a is the key antibacterial substance of Bacillus amyloliquefaciens D2WM against the pathogen Dickeya chrysanthemi. Eur. J. Plant Pathol. 2019, 155, 393–404. [Google Scholar] [CrossRef]
- Chen, L.; Wang, X.; Liu, Y. Contribution of macrolactin in Bacillus velezensis CLA178 to the antagonistic activities against Agrobacterium tumefaciens C58. Arch Microbiol. 2021, 203, 1743–1752. [Google Scholar] [CrossRef]
- Altena, K.; Guder, A.; Cramer, C.; Bierbaum, G. Biosynthesis of the lantibiotic mersacidin: Organization of a type B lantibiotic gene cluster. Appl. Environ. Microbiol. 2000, 66, 2565–2571. [Google Scholar] [CrossRef]
- Herzner, A.M.; Dischinger, J.; Szekat, C.; Josten, M.; Schmitz, S.; Yakéléba, A.; Reinartz, R.; Jansen, A.; Sahl, H.G.; Piel, J.; et al. Expression of the lantibiotic mersacidin in Bacillus amyloliquefaciens FZB42. PLoS ONE 2011, 6, e22389. [Google Scholar] [CrossRef]
- Stadermann, K.B.; Blom, J.; Borgmeier, C.; Sciberras, N.; Herbold, S.; Kipker, M.; Meurer, G.; Molck, S.; Petri, D.; Pelzer, S.; et al. First complete genome sequence of Bacillus glycinifermentans B-27. J. Biotechnol. 2017, 257, 187–191. [Google Scholar] [CrossRef]
- Chowdhury, S.P.; Hartmann, A.; Gao, X.; Borriss, R. Biocontrol mechanism by root-associated Bacillus amyloliquefaciens FZB42–a review. Front. Microbiol. 2015, 6, 780. [Google Scholar] [CrossRef] [PubMed]
- Nannan, C.; Vu, H.Q.; Gillis, A.; Caulier, S.; Nguyen, T.T.T.; Mahillon, J. Bacilysin within the Bacillus subtilis group: Gene prevalence versus antagonistic activity against Gram-negative foodborne pathogens. J. Biotechnol. 2021, 327, 28–35. [Google Scholar] [CrossRef]
- Özcengiz, G.; Öğülür, İ. Biochemistry, genetics and regulation of bacilysin biosynthesis and its significance more than an antibiotic. N. Biotechnol. 2015, 32, 612–619. [Google Scholar] [CrossRef]
- Chen, X.H.; Koumoutsi, A.; Scholz, R.; Borriss, R. More than anticipated–production of antibiotics and other secondary metabolites by Bacillus amyloliquefaciens FZB42. J. Mol. Microbiol. Biotechnol. 2009, 16, 14–24. [Google Scholar] [CrossRef]
- Dimopoulou, A.; Theologidis, I.; Benaki, D.; Koukounia, M.; Zervakou, A.; Tzima, A.; Diallinas, G.; Hatzinikolaou, D.G.; Skandalis, N. Direct antibiotic activity of bacillibactin broadens the biocontrol range of Bacillus amyloliquefaciens MBI600. Msphere 2021, 6, 10–1128. [Google Scholar] [CrossRef]
- Hoff, G.; Arguelles Arias, A.; Boubsi, F.; Pršić, J.; Meyer, T.; Ibrahim, H.M.; Steels, S.; Luzuriaga, P.; Legras, A.; Franzil, L.; et al. Surfactin stimulated by pectin molecular patterns and root exudates acts as a key driver of the Bacillus-plant mutualistic interaction. MBio 2021, 12, e0177421. [Google Scholar] [CrossRef] [PubMed]
- Ongena, M.; Jacques, P. Bacillus lipopeptides: Versatile weapons for plant disease biocontrol. Trends Microbiol. 2008, 16, 115–125. [Google Scholar] [CrossRef]
- Seydlová, G.; Svobodová, J. Review of surfactin chemical properties and the potential biomedical applications. Cent. Eur. J. Med. 2008, 3, 123–133. [Google Scholar] [CrossRef]
- Kiesewalter, H.T.; Lozano-Andrade, C.N.; Wibowo, M.; Strube, M.L.; Maróti, G.; Snyder, D.; Jørgensen, T.S.; Larsen, T.O.; Cooper, V.S.; Weber, T.; et al. Genomic and chemical diversity of Bacillus subtilis secondary metabolites against plant pathogenic fungi. mSystems. 2021, 6, e00770-20. [Google Scholar] [CrossRef]
- Fazle Rabbee, M.; Baek, K.H. Antimicrobial activities of lipopeptides and polyketides of Bacillus velezensis for agricultural applications. Molecules 2020, 25, 4973. [Google Scholar] [CrossRef]
- Koumoutsi, A.; Chen, X.H.; Henne, A.; Liesegang, H.; Hitzeroth, G.; Franke, P.; Vater, J.; Borriss, R. Structural and functional characterization of gene clusters directing nonribosomal synthesis of bioactive cyclic lipopeptides in Bacillus amyloliquefaciens strain FZB42. J. Bacteriol. 2004, 186, 1084–1096. [Google Scholar] [CrossRef] [PubMed]
- Gong, Q.; Zhang, C.; Lu, F.; Zhao, H.; Bie, X.; Lu, Z. Identification of bacillomycin D from Bacillus subtilis fmbJ and its inhibition effects against Aspergillus flavus. Food Control 2014, 36, 8–14. [Google Scholar] [CrossRef]
- Gu, Q.; Yang, Y.; Yuan, Q.; Shi, G.; Wu, L.; Lou, Z.; Huo, R.; Wu, H.; Borriss, R.; Gao, X. Bacillomycin D produced by Bacillus amyloliquefaciens is involved in the antagonistic interaction with the plant-pathogenic fungus Fusarium graminearum. Appl. Environ. Microbiol. 2017, 83, e01075-17. [Google Scholar] [CrossRef]
- Jin, P.; Wang, H.; Tan, Z.; Xuan, Z.; Dahar, G.Y.; Li, Q.X.; Miao, W.; Liu, W. Antifungal mechanism of bacillomycin D from Bacillus velezensis HN-2 against Colletotrichum gloeosporioides Penz. Pestic. Biochem. Physiol. 2020, 163, 102–107. [Google Scholar] [CrossRef] [PubMed]
- Lin, F.; Huang, Z.; Chen, Y.; Zhou, L.; Chen, M.; Sun, J.; Lu, Z.; Lu, Y. Effect of combined Bacillomycin D and chitosan on growth of Rhizopus stolonifer and Botrytis cinerea and cherry tomato preservation. J. Sci. Food Agric. 2021, 101, 229–239. [Google Scholar] [CrossRef] [PubMed]
- Zeriouh, H.; Romero, D.; García-Gutiérrez, L.; Cazorla, F.M.; de Vicente, A.; Perez-Garcia, A. The iturin-like lipopeptides are essential components in the biological control arsenal of Bacillus subtilis against bacterial diseases of cucurbits. Mol. Plant Microbe Interact. 2011, 24, 1540–1552. [Google Scholar] [CrossRef]
- Köhl, J.; Kolnaar, R.; Ravensberg, W.J. Mode of action of microbial biological control agents against plant diseases: Relevance beyond efficacy. Front. Plant Sci. 2019, 10, 845. [Google Scholar] [CrossRef]
- Lastochkina, O.; Garshina, D.; Allagulova, C.; Fedorova, K.; Koryakov, I.; Vladimirova, A. Application of Endophytic Bacillus subtilis and Salicylic Acid to Improve Wheat Growth and Tolerance under Combined Drought and Fusarium Root Rot Stresses. Agronomy 2020, 10, 1343. [Google Scholar] [CrossRef]
- Chen, K.; Tian, Z.; He, H.; Long, C.; Jiang, F. Bacillus species as potential biocontrol agents against citrus diseases. Biol. Control 2020, 151, 104419. [Google Scholar] [CrossRef]
- Kumar, A.P.; Swamy, J.S.; Gouthami, P.; Santhoshini, C.N.R. A Review on Bio-Based Control of Post-Harvest Diseases. Int. J. Plant Soil Sci. 2023, 35, 212–222. [Google Scholar] [CrossRef]
- Dukare, A.S.; Paul, S.; Nambi, V.E.; Gupta, R.K.; Singh, R.; Sharma, K.; Vishwakarma, R.K. Exploitation of microbial antagonists for the control of postharvest diseases of fruits: A review. Crit. Rev. Food. Sci. Nutr. 2019, 59, 1498–1513. [Google Scholar] [CrossRef] [PubMed]
- Zhou, Q.; Fu, M.; Xu, M.; Chen, X.; Qiu, J.; Wang, F.; Yan, R.; Wang, J.; Zhao, S.; Xin, X. Application of antagonist Bacillus amyloliquefaciens NCPSJ7 against Botrytis cinerea in postharvest Red Globe grapes. Food Sci. Nutr. 2020, 8, 1499–1508. [Google Scholar] [CrossRef] [PubMed]
- Hassan, E.A.; Mostafa, Y.S.; Alamri, S.; Hashem, M.; Nafady, N.A. Biosafe management of Botrytis grey mold of strawberry fruit by novel bioagents. Plants 2021, 10, 2737. [Google Scholar] [CrossRef]
- Wang, X.L.; Yuan, Z.X.; Shi, Y.Q.; Cai, F.H.; Zhao, J.R.; Wang, J.Z.; Wang, Y.P. Bacillus amyloliquefaciens HG01 induces resistance in loquats against anthracnose rot caused by Colletotrichum acutatum. Postharvest Biol. Technol. 2020, 160, 111034. [Google Scholar] [CrossRef]
- Nifakos, K.; Tsalgatidou, P.C.; Thomloudi, E.E.; Skagia, A.; Kotopoulis, D.; Baira, E.; Delis, C.; Papadimitriou, K.; Markellou, E.; Venieraki, A.; et al. Genomic analysis and secondary metabolites production of the endophytic Bacillus velezensis Bvel1: A biocontrol agent against Botrytis cinerea causing bunch rot in post-harvest table grapes. Plants 2021, 10, 1716. [Google Scholar] [CrossRef]
- Wenneker, M.; Thomma, B.P. Correction to: Latent postharvest pathogens of pome fruit and their management: From single measures to a systems intervention approach. Eur. J. Plant Pathol. 2020, 156, 663–681. [Google Scholar] [CrossRef]
- Arrebola, E.; Sivakumar, D.; Korsten, L. Effect of volatile compounds produced by Bacillus strains on postharvest decay in citrus. Biol. Control. 2010, 53, 122–128. [Google Scholar] [CrossRef]
- Zheng, M.; Shi, J.; Shi, J.; Wang, Q.; Li, Y. Antimicrobial effects of volatiles produced by two antagonistic Bacillus strains on the anthracnose pathogen in postharvest mangos. Biol. Control. 2013, 65, 200–206. [Google Scholar] [CrossRef]
- Lin, F.; Xue, Y.; Huang, Z.; Jiang, M.; Lu, F.; Bie, X.; Miao, S.; Lu, Z. Bacillomycin D inhibits growth of Rhizopus stolonifer and induces defense-related mechanism in cherry tomato. Appl. Microbiol. Biotechnol. 2019, 103, 7663–7674. [Google Scholar] [CrossRef]
- Xue, Y.; Sun, J.; Lu, F.; Bie, X.; Li, Y.; Lu, Y.; Lu, Z.; Lin, F. Transcriptomic analysis reveals that bacillomycin D-C16 induces multiple pathways of disease resistance in cherry tomato. BMC Genom. 2023, 24, 218. [Google Scholar]
- Brock, A.K.; Berger, B.; Mewis, I.; Ruppel, S. Impact of the PGPB Enterobacter radicincitans DSM 16656 on growth, glucosinolate profile, and immune responses of Arabidopsis thaliana. Microb. Ecol. 2013, 65, 661–670. [Google Scholar] [CrossRef]
- López-Bucio, J.; Campos-Cuevas, J.C.; Hernández-Calderón, E.; Velásquez-Becerra, C.; Farías-Rodríguez, R.; Macías-Rodríguez, L.; Valencia-Cantero, E. Bacillus megaterium rhizobacteria promote growth and alter root-system architecture through an auxin-and ethylene-independent signaling mechanism in Arabidopsis thaliana. Mol. Plant Microbe Interact. 2007, 20, 207–217. [Google Scholar] [CrossRef] [PubMed]
- Dahmani, M.A.; Desrut, A.; Moumen, B.; Verdon, J.; Mermouri, L.; Kacem, M.; Coutos-Thevenot, P.; Kaid-Harche, M.; Berges, T.; Vriet, C. Unearthing the plant growth-promoting traits of Bacillus megaterium RmBm31, an endophytic bacterium isolated from root nodules of Retama monosperma. Front. Plant Sci. 2020, 11, 124. [Google Scholar] [CrossRef] [PubMed]
- Chu, T.N.; Bui, L.V.; Hoang, M.T.T. Pseudomonas PS01 isolated from maize rhizosphere alters root system architecture and promotes plant growth. Microorganisms 2020, 8, 471. [Google Scholar] [CrossRef] [PubMed]
- Vacheron, J.; Desbrosses, G.; Bouffaud, M.L.; Touraine, B.; Moenne-Loccoz, Y.; Muller, D. Plant growth-promoting rhizobacteria and root system functioning. Front. Plant Sci. 2013, 4, 356. [Google Scholar] [CrossRef]
- Thomloudi, E.E.; Tsalgatidou, P.C.; Baira, E.; Papadimitriou, K.; Venieraki, A.; Katinakis, P. Genomic and metabolomic insights into secondary metabolites of the novel Bacillus halotolerans Hil4, an endophyte with promising antagonistic activity against gray mold and plant growth promoting potential. Microorganisms 2021, 9, 2508. [Google Scholar] [CrossRef]
- Ryu, C.M.; Farag, M.A.; Hu, C.H.; Reddy, M.S.; Wei, H.X.; Paré, P.W.; Kloepper, J.W. Bacterial volatiles promote growth in Arabidopsis. Proc. Natl. Acad. Sci. USA 2003, 100, 4927–4932. [Google Scholar] [CrossRef]
- He, A.L.; Zhao, L.Y.; Ren, W.; Li, H.R.; Paré, P.W.; Zhao, Q.; Zhang, J.L. A volatile producing Bacillus subtilis strain from the rhizosphere of Haloxylon ammodendron promotes plant root development. Plant Soil. 2023, 486, 661–680. [Google Scholar] [CrossRef]

| Fungal Growth Inhibition (%) | ||
|---|---|---|
| Phytopathogen | Diffusible Compounds | VOCs |
| Verticillium dahliae | 64.72 ± 3.72 | 1.50 ± 0.39 |
| Colletotrichum acutatum | 63.15 ± 4.54 | 12.74 ± 7.20 |
| Botrytis cinerea | 66.77 ± 7.64 | 18.42 ± 1.51 |
| FORL | 70.02 ± 5.50 | 13.19 ± 3.01 |
| Bacillus velezensis Strains | orthoANI % | dDDH % |
|---|---|---|
| Β.Β.Sf.2 | 100 | 100 |
| B.velezensis strain C1 (CP064091.1) | 99.09 | 93 |
| B.velezensis strain JS25R (CP009679.1) | 99.19 | 92.9 |
| B.velezensis FZB42′ (NC 009725.2) | 98.35 | 85.5 |
| B.velezensis strain YJ11-1-4 (CP011347.1) | 98.34 | 85.1 |
| B.velezensis strain MBI600 (CP094686.1) | 98.35 | 85 |
| B.velezensis strain UA2208 (CP097586.1) | 98.3 | 84.7 |
| B.velezensis strain FJAT-46737 (CP044133.1) | 98.2 | 84.5 |
| B. velezensisstrain 8-2 (CP028439.1) | 97.73 | 79.8 |
| B.velezensis strain Yao (CP090905.1) | 97.62 | 79.7 |
| B.velezensis strain NRRL B-41580 T (NZ_LLZC00000000.1) 1 | 99.40 | 95 |
| Regions | Most Similar Known Cluster | MIBiG ID (% of Genes Show Similarity) | Size | Predicted Biosynthetic Gene Clusters | Metabolite |
|---|---|---|---|---|---|
| 1.1 | acn | BGC0000616 (100%) | 51,791 nt | RiPP | Amylocyclicin |
| dhb | BGC0001185 (100%) | NRPS | Bacillibactin | ||
| 1.2 | - | - | 68,421 nt | NRPS | - |
| 1.3 | bac | BGC0001184 (100%) | 41,419 nt | Other | Bacilycin |
| 1.4 | mrs | BGC0000527 (100%) | 23,189 nt | Lanthipeptide | Mersacidin |
| 4.1 | srf | BGC0000433 (82%) | 65,408 nt | NRPS | Surfactin |
| 5.1 | - | - | 12,148 nt | Phosphonate | - |
| 6.1 | btr | BGC0000693 (7%) | 41,245 nt | PKS | Butirosin A |
| 6.2 | - | - | 20,741 nt | Terpene | - |
| 6.3 | pksx | BGC0000181 (100%) | 86,374 nt | TransAT-PKS | Macrolactin H |
| 6.4 | bae | BGC0001089 (100%) | 102,629 nt | NRPS,transAT-PKS | Bacillaene |
| 7.1 | fen | BGC0001095 (93%) | 137,509 nt | NRPS | Fengycin |
| bmy | BGC0001090 (100%) | NRPS, Polyketide | BacillomycinD | ||
| 7.2 | - | - | 21,884 nt | Terpene | - |
| 7.3 | - | - | 41,101 nt | T3PKS | - |
| 7.4 | dif | BGC0000176 (100%) | 93,790 nt | TransAT-PKS | Difficidin |
Disclaimer/Publisher’s Note: The statements, opinions and data contained in all publications are solely those of the individual author(s) and contributor(s) and not of MDPI and/or the editor(s). MDPI and/or the editor(s) disclaim responsibility for any injury to people or property resulting from any ideas, methods, instructions or products referred to in the content. |
© 2025 by the authors. Licensee MDPI, Basel, Switzerland. This article is an open access article distributed under the terms and conditions of the Creative Commons Attribution (CC BY) license (https://creativecommons.org/licenses/by/4.0/).
Share and Cite
Douka, D.; Spantidos, T.-N.; Katinakis, P.; Venieraki, A. Unveiling the Genomic Basis of Antagonism and Plant Growth Promotion in the Novel Endophyte Bacillus velezensis Strain B.B.Sf.2. DNA 2025, 5, 23. https://doi.org/10.3390/dna5020023
Douka D, Spantidos T-N, Katinakis P, Venieraki A. Unveiling the Genomic Basis of Antagonism and Plant Growth Promotion in the Novel Endophyte Bacillus velezensis Strain B.B.Sf.2. DNA. 2025; 5(2):23. https://doi.org/10.3390/dna5020023
Chicago/Turabian StyleDouka, Dimitra, Tasos-Nektarios Spantidos, Panagiotis Katinakis, and Anastasia Venieraki. 2025. "Unveiling the Genomic Basis of Antagonism and Plant Growth Promotion in the Novel Endophyte Bacillus velezensis Strain B.B.Sf.2" DNA 5, no. 2: 23. https://doi.org/10.3390/dna5020023
APA StyleDouka, D., Spantidos, T.-N., Katinakis, P., & Venieraki, A. (2025). Unveiling the Genomic Basis of Antagonism and Plant Growth Promotion in the Novel Endophyte Bacillus velezensis Strain B.B.Sf.2. DNA, 5(2), 23. https://doi.org/10.3390/dna5020023

